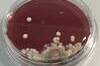
Lebensmittelmikrobiologie Labor

Der erste Kontakt ...
Windkanal
................................................................................................................................................................................................
für Kita's und Grundschulen
Den Kindern wird vermittelt, warum ein Flugzeug fliegt und wie es steuern kann. Wichtig sind die Flügel, die das Flugzeug in der Luft halten, der Antrieb über die Triebwerke, damit es sich bewegen kann und natürlich Ruder und Klappen, damit man die Richtung ändern kann. Wie die Kräfte entstehen, wird mit einfachen Experimenten erklärt.
Gruppengröße: bis 20 SchülerInnen
Kontakt: Monika Riedel, Torsten Tubacki aerodynamik_labor (at) haw-hamburg (dot) de